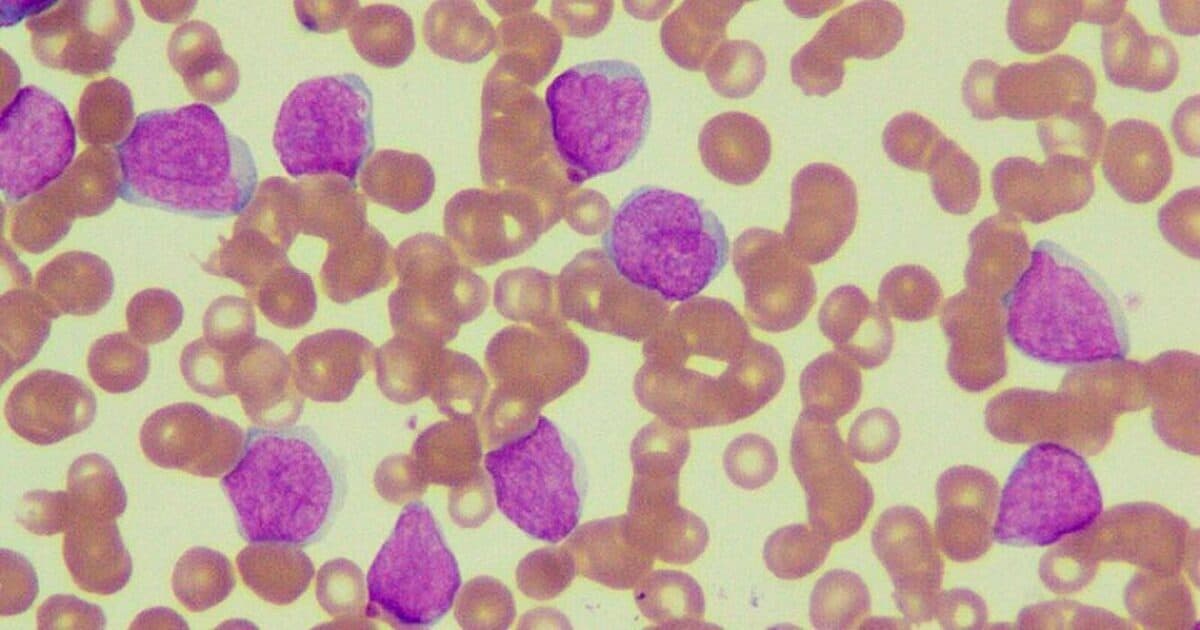
Medical Imaging and Pediatric and Adolescent Hematologic Cancer Risk

Part 1 The Physician-Brain: Why Your Greatest Assets Are Also Your Greatest Liabilities
By Lauro Amezcua-Patino MD
Published on 11/28/2025
You made a split-second decision at 3 a.m. that saved a life. You recognized a pattern in lab values that six other clinicians missed. You walked into a room where a family was falling apart and somehow found the words that held them together. These are not just moments of your career but shining examples of your exceptional performance as a physician.
And then you went home, replayed that decision for two hours, questioned whether you missed something, and lay awake wondering if you're good enough. These are not just personal struggles, but the shared challenges of the physician community.
Welcome to the physician brain.
We are not like other professionals. That's not arrogance; it's a recognition of our unique cognitive architecture. The same cognitive architecture that makes us exceptional diagnosticians also makes us vulnerable to perfectionism, burnout, and a particularly vicious brand of self-criticism. We've been selected, trained, and reinforced for traits that serve our patients brilliantly but can quietly destroy us.
The question is: Do we understand our own operating system well enough to protect it?
What follows is an examination of what makes us tick, what makes us crack, and why the physician brain is both our greatest strength and our most profound vulnerability.
The Neurobiological Assets: What Makes Us Different
Let's start with what works. Physicians are cognitive athletes. Our brains have been shaped, through selection and training, to perform tasks that would overwhelm most nervous systems.
Pattern Recognition on Steroids
The human brain is a pattern-matching machine, but the physician's brain operates at a different level entirely. Years of deliberate practice have strengthened connections between the inferior frontal gyrus and temporal cortex, regions critical for rapid pattern recognition. When you walk into a room and "just know" something is wrong before touching the patient, that's not magic. It's your brain conducting a symphony of parallel processing, integrating visual cues, contextual information, and ten thousand prior experiences in milliseconds.
Studies using eye-tracking technology show that experienced physicians fixate on diagnostically relevant information faster and more accurately than novices. Your brain has literally rewired itself to see what matters and filter what doesn't.
Decision-Making Under Pressure
Most people's prefrontal cortex shuts down under acute stress; ours doesn't.
The physician's brain has developed an unusual capacity to maintain executive function during sympathetic activation. When adrenaline floods your system during a code, your amygdala signals danger, but your ventromedial prefrontal cortex simultaneously inhibits panic and maintains access to procedural memory. You run the algorithm. You make decisions. You don't freeze.
This is the result of repeated exposure to high-stakes scenarios during training. Your stress response has been conditioned, and your prefrontal regions have learned to override limbic signals of panic.
Delayed Gratification and Empathy
Medical training is an eleven-year exercise in impulse control. That takes a specific neurobiological profile. Physicians tend to have robust prefrontal dopaminergic systems that allow us to value future rewards over immediate ones. This capacity will enable us to delay diagnostic closure, tolerate ambiguity, and wait for the right moment to intervene.
Despite stereotypes, most of us entered medicine because our empathy circuits work well. The anterior insula and anterior cingulate cortex, core regions of the empathy network, light up when we witness suffering. We feel, therefore we care. But sustained activation of empathy circuits without adequate recovery leads to compassion fatigue, a literal exhaustion of the neurobiological systems that allow us to connect with suffering.
The Neurobiological Deficits: When Strengths Become Vulnerabilities
Now the uncomfortable part. The same traits that make us excellent physicians create systematic vulnerabilities.
Perfectionism Isn't a Personality Trait; It's a Neural Trap
Perfectionism is baked into our neurocircuitry. The same prefrontal rigidity that allows precise clinical reasoning also creates inflexible self-standards. Our anterior cingulate cortex becomes the neurobiological foundation of rumination.
You didn't just make a mistake; your brain replays it in an endless loop, strengthening the neural pathway each time. The amygdala tags errors with emotional salience, ensuring they're encoded in long-term memory with perfect fidelity. We can remember every patient we've lost but struggle to recall our successes.
Intolerance of Uncertainty in an Uncertain World
Medicine is selected for people who crave intellectual closure. But medicine is nothing but uncertainty.
The physician's brain has an unusually active anterior insula, the region associated with disgust and discomfort. This heightened interoceptive awareness makes us exquisitely sensitive to the feeling of "not knowing." Most people can shrug off ambiguity. We experience it almost physically.
This drives us to order more tests, consult more specialists, and read one more article at midnight. It's not just due diligence. It's our nervous system trying to resolve the intolerable sensation of uncertainty.
The Burnout Brain Isn't Lazy; It's Depleted
Burnout is not a psychological weakness. It's neurobiological depletion.
Chronic stress dysregulates the hypothalamic-pituitary-adrenal axis, leading to disrupted cortisol rhythms. The prefrontal cortex begins to show actual structural changes. Gray matter volume decreases in regions responsible for emotional regulation.
What appears to be apathy is actually anhedonia. What looks like cynicism is a prefrontal cortex that can no longer suppress amygdala-driven negativity. What seems to be inefficiency is cognitive exhaustion.
The burnout brain isn't broken. It's self-protecting by shutting down non-essential systems. Unfortunately, compassion and joy are classified as "non-essential" during survival mode.
Biology Meets Culture
You can't separate the physician brain from the physician experience.
Yes, we self-selected for certain temperamental traits. But medical culture then systematically amplified our vulnerabilities. We were trained to ignore hunger, bladder signals, and fatigue. We learned that asking for help is seen as a weakness. We internalized the message that our needs are secondary to everyone else's.
This isn't just culture; it's neuroplastic conditioning. Your brain literally learned to suppress interoceptive signals from your body. This was adaptive during residency. It becomes maladaptive in the long term.
The social context matters enormously. Physicians working in supportive systems with autonomy exhibit distinct neural patterns compared with those in high-demand, low-control environments. And we can't ignore structural inequality. Women physicians and physicians of color face additional neurobiological stressors from discrimination and stereotype threat. These aren't "in your head." They're measurable as chronic stress biomarkers.
The physician- brain doesn't exist in isolation. It exists in a healthcare system that has systematically exploited its greatest strengths while providing inadequate support for its inherent vulnerabilities.
What We Must Remember
Understanding the physician-brain isn't an academic exercise. It's survival intelligence.
We are not failing when we struggle. We're experiencing the predictable consequences of a neurobiological profile that was selected for extreme performance without adequate recovery systems.
The human brain is extraordinary. It can integrate massive amounts of information, make life-or-death decisions under pressure, maintain empathy in the face of suffering, and delay gratification for more than a decade in pursuit of expertise.
But it is not invincible.
If we understand our own cognitive architecture, both its strengths and its vulnerabilities, we can design lives and systems that protect it. We can recognize when perfectionism has crossed into rumination. We can identify the early neural signatures of burnout before structural changes occur. We can build recovery into the rhythm of our work rather than treating it as optional.
We ask our patients to understand their bodies. It's time we understood our own.
Dr. Amezcua-Patino is a psychiatrist and neuropsychiatrist committed to advancing ethical, accessible, and neuroscience-informed mental health care.
Discussion
Join the conversation! Login if you already have an account, or create an account. We would love to hear your perspective.
Comments
0Loading comments…
Your Next Read